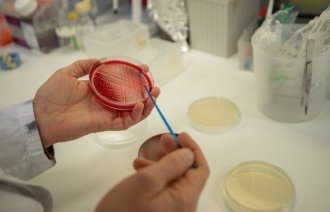
Stafylokokk, Universitetet i Tromsø Bildet viser hender og en petriskål.

Sepsis kan oppdages tidlig med disse verktøyene
Fagutvikling
Bedre med to lag hansker
Cochrane
Bakterier som dreper
Nyheter
Bakterieflora fra gulv til pasient?
Fagutvikling
Stell og fjerning av perifer venekanyle
Fagutvikling
Erfaringer med luftsmitte-isolerte pasienter
Fagutvikling
Sykehusstandard og infeksjonskontrollarbeid
Fagutvikling
– En glemt arena?
Fagutvikling
Husk handvask
Fagutvikling
Annonse